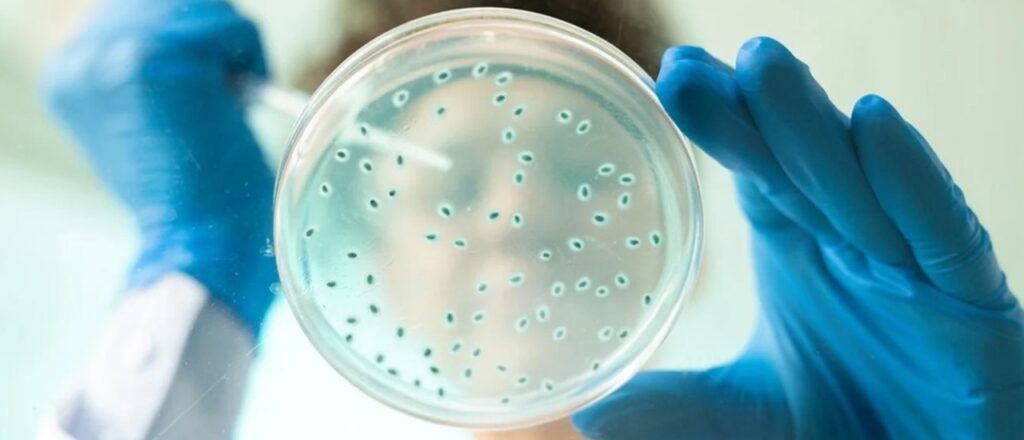

La diversidad genética de Brettanomyces es un factor clave en su capacidad de adaptación y supervivencia en una amplia gama de entornos productivos, y permite a la levadura prosperar en condiciones desafiantes, como fermentaciones de cerveza con alto contenido de etanol o vinos tratados con SO₂. Con el objetivo de comprender y profundizar este tema, así como para ampliar su conocimiento y evitar la contaminación y consiguientes defectos en los vinos, científicos de la Universitat Rovira i Virgili de España, hicieron un análisis detallado destacando su variación en la ploidía, plasticidad genómica, diversidad fenotípica, eventos de hibridación y las implicaciones productivas de estos rasgos.
El género de levaduras Brettanomyces, particularmente Brettanomyces bruxellensis, ha sido ampliamente estudiado debido a su notable diversidad genética y su capacidad para adaptarse a una variedad de entornos industriales como la elaboración de vino, cerveza, kombucha y bioetanol.
Su presencia puede cambiar completamente las propiedades organolépticas del producto, debido principalmente a la producción de metabolitos secundarios característicos. Así pues, Brettanomyces está asociada a procesos de fermentación en los que puede considerarse como un agente perjudicial (por ejemplo, elaboración de vino, sidra o producción de bioetanol) o como un microorganismo beneficioso (por ejemplo, elaboración de cervezas específicas o kombucha). Esta levadura es conocida por su capacidad de prosperar en diferentes nichos industriales gracias a su plasticidad genómica, hibridación, variación en la ploidía y otros mecanismos evolutivos. Este artículo describe un análisis detallado de la diversidad genética de Brettanomyces, destacando su variación en la ploidía, plasticidad genómica, diversidad fenotípica, eventos de hibridación y las implicaciones productivas de estos rasgos.
Breve historia del género Dekkera/Brettanomyces
En 1904 Hjelte Clausen aisló por primera vez levaduras de la especie Brettanomyces en el laboratorio de investigación de Carlsberg, donde se la consideró responsable de realizar la fermentación secundaria y el desarrollo de los sabores característicos de las mejores cervezas inglesas. Su nombre viene de brettano por su procedencia de Bretaña y myces del griego myketes o fungus en latín. Curiosamente, este aislamiento inicial de Brettanomyces dio como resultado el primer microorganismo patentado de la historia (UK patent GB190328184). La primera investigación sistemática de las levaduras Brettanomyces fue realizada y publicada por Mathieu Custers en 1940, quien caracterizó 17 cepas diferentes aisladas de cervezas inglesas y belgas. Más tarde, en 1956, Peynaud y Domercq describieron la presencia de aislados de Brettanomyces en uvas y vinos, como organismos contaminantes.
Inicialmente, la clasificación de esta especie se basaba únicamente en unas pocas variantes que se reproducían asexualmente (anamórficas). Sin embargo, unas décadas más tarde, se observó la formación de ascosporas en algunas cepas y el género Dekkera se introdujo en la taxonomía como la contraparte teleomórfica (sexual) de Brettanomyces. Por lo tanto, en las clasificaciones actuales, las levaduras que pertenecen al género Brettanomyces no forman esporas (anamorfas), mientras que el nombre del género Dekkera describe las variantes formadoras de esporas (teleomorfas) de la levadura, aunque se utilizan a menudo como sinónimos. Actualmente, se describen cinco especies de Brettanomyces/Dekkera, basadas en el análisis molecular de los géneros: los anamorfos B. bruxellensis, B. anomalus, B. custersianus, B. naardenensis y B. nanus, existiendo teleomorfos para las dos primeras especies, D. bruxellensis y D. anómala. Entre estas, la especie mayoritaria en procesos fermentativos y la más estudiada es B. bruxellensis.
Variación en la ploidía y plasticidad genómica
Uno de los aspectos más llamativos de B. bruxellensis es su variación en la ploidía, que juega un papel crucial en su diversidad genética y adaptabilidad. Las cepas B. bruxellensis presentan diploides, autotriploides y alotetraploides, lo que les permite adaptarse a entornos productivos específicos, tales como la elaboración de cerveza o bioetanol. Por ejemplo, se ha encontrado que las cepas triploides son comunes en la elaboración de cerveza debido a su mayor resistencia a los estreses de fermentación. Recientemente, representaron la diversidad genética de las subpoblaciones de B. bruxellensis y el nivel de ploidía (Figura 1) basándose en una serie de estudios previos.

Además de la ploidía, la plasticidad genómica de Brettanomyces juega un papel esencial en su capacidad para adaptarse. Esta levadura muestra variaciones estructurales en su genoma, incluidas reorganizaciones cromosómicas, duplicaciones y deleciones que le permiten sobrevivir en condiciones de fermentación adversas, como altas concentraciones de etanol y bajos niveles de nutrientes. Un estudio reveló que las reorganizaciones genómicas en B. bruxellensis mejoran su versatilidad metabólica, permitiéndole utilizar fuentes de carbono como celobiosa y lactosa, que son inaccesibles para otras levaduras.
Alta variabilidad genética inter e intraespecífica
En 2007, Woolfit y otros publicaron el primer estudio del genoma de la cepa B. bruxellienses CBS2499, responsable del deterioro de vinos franceses, y proporcionaron una primera visión de la naturaleza peculiar del genoma B. bruxellensis. La obtención de genomas completos de alta calidad de las cinco especies de Brettanomyces reveló dos grupos genéticos distintos: uno formado por B. nanus y B. naardenensis, y el otro por B. bruxellensis, B. anomalus y B. custersianus. La similitud promedio entre los genomas de estas especies varió entre el 60,6% y el 77,1%, mostrando que las especies de Brettanomyces están relativamente distantes entre sí. En comparación, las especies más distantes en el género Saccharomyces muestran una identidad del 79,9%. El estudio del genoma de estas especies de Brettanomyces demostró la presencia de expansiones genéticas relacionadas con la fermentación y la asimilación de nitrógeno, así como 12 eventos de transferencia horizontal de genes que podrían explicar la capacidad de B. bruxellensis y B. anomalus para utilizar sacarosa. Estas características genéticas también se encontraron en poblaciones de S. cerevisiae tras su domesticación, lo que sugiere que Brettanomyces puede ser un modelo útil para estudiar la adaptación de las levaduras a ambientes fermentativos.
B. bruxellensis también es conocida por su alta variabilidad genética intraespecífica, que ha sido revelada a través de estudios de asociación del genoma completo y tipificación de secuencias multilocus. Estos estudios han identificado linajes genéticos distintos que se correlacionan con nichos industriales específicos. Recientemente, Lebleux y otros, en 2021), utilizando un método adaptado de PCR con ADN polimórfico amplificado al azar (RAPD) y tres cebadores diferentes en aislados de B. bruxellensis, han encontrado una alta correlación entre los resultados obtenidos con uno de estos cebadores y un análisis previo de microsatélites, lo que permitió agrupar los aislados en cuatro grupos genéticos de forma más rápida y económica. Además, se investigó la correlación entre los grupos genéticos y el polimorfismo celular mediante imágenes microscópicas analizadas con deep learning, pudiéndose predecir el grupo genético con una precisión del 96,6% mediante una red neuronal convolucional.
Perspectivas genómicas de los estudios de población
Los estudios genómicos de poblaciones han proporcionado información sobre la adaptación de Brettanomyces a entornos productivos específicos. Se han identificado grupos genéticos de B. bruxellensis adaptados a diferentes nichos, lo que revela una clara diferenciación entre las poblaciones que habitan en entornos de elaboración de vino y cerveza. Oro y otros, en 2019, comprobaron que las cepas aisladas tanto del viñedo como de la bodega pertenecían a biotipos comunes y dominantes, lo que sugiere que el viñedo puede ser la fuente de contaminación de B. bruxellensis en la bodega. Además, las cepas aisladas de la elaboración de vino han desarrollado una mayor capacidad para entrar en un estado viable pero no cultivable (VBNC); un mecanismo de supervivencia que les permite persistir en condiciones difíciles. No obstante, B. bruxellensis es difícil de aislar de entornos naturales debido a su baja difusión, poca presencia en la superficie de la uva, baja capacidad competitiva, crecimiento lento y su estado VBNC, incluso cuando se utilizan medios selectivos para su aislamiento. Un estudio sobre las cepas vinícolas de Brettanomyces sugirió que la capacidad de entrar en el estado VBNC está relacionada con su adaptación a los estreses de fermentación, como el uso de agentes antimicrobianos y altas concentraciones de etanol.
Aunque tradicionalmente se considera un organismo de deterioro en fermentaciones de producción de bioetanol, se ha descubierto una cepa B. bruxellensis capaz de competir exitosamente con S. cerevisiae sin afectar la producción de etanol. Además, B. bruxellensis tiene características como la capacidad de consumir nitrato y dextrinas, lo que podría expandir el rango de sustratos utilizados en la producción industrial de bioetanol.
Este tipo de mecanismos de supervivencia refuerza la idea de que la presión antropogénica en los entornos industriales ha sido un motor clave en la evolución y diversificación de Brettanomyces.
Hibridación y flujo génico
La hibridación ha sido un proceso evolutivo importante para Brettanomyces, ya que ha dado lugar a nuevas cepas con características mejoradas. Se ha documentado la existencia de cepas alotetraploides que surgieron de eventos de hibridación entre Brettanomyces y otras especies de levaduras. Estas cepas híbridas han demostrado tener mayor resistencia al estrés y mayor versatilidad metabólica.
Los eventos de hibridación entre especies no son raros en los hongos y también se observan en Saccharomyces sensu estricto. Por ejemplo, la levadura de cerveza S. pastorianus es una especie híbrida de S. cerevisiae y S. eubayanus. Los genomas híbridos recién formados tienden a ser muy inestables como se ha mostrado anteriormente para híbridos de Saccharomyces. Los mecanismos que impulsan la estabilización del genoma podrían explicar la extrema variabilidad cariotípica observada en B. bruxellensis.
El flujo génico entre las poblaciones de Brettanomyces también contribuye a su diversidad genética. La transferencia de cepas de levaduras entre diferentes entornos industriales ha permitido el intercambio de rasgos adaptativos entre las poblaciones. Sin embargo, este flujo génico puede complicar los esfuerzos por controlar Brettanomyces en la vinificación, donde su capacidad de resistencia a SO₂ y la producción de compuestos fenólicos volátiles es indeseable.
Impacto fenotípico de la diversidad genética
La diversidad genética de Brettanomyces se refleja no sólo en su genoma sino también en sus rasgos fenotípicos, que tienen un impacto significativo en los procesos industriales. Uno de los rasgos fenotípicos más importantes es la producción de fenoles volátiles, como el 4-etilfenol y el 4-etilguaiacol, que son responsables del característico aroma a “Brett” en vino y cerveza. Diferentes linajes genéticos de Brettanomyces varían en su capacidad de producir estos compuestos, lo que tiene consecuencias diferentes según el contexto productivo. En la elaboración de cerveza, especialmente en estilos tradicionales belgas como las cervezas Lambics y Gueuzes, estos compuestos son deseados ya que contribuyen a su característico sabor y aportan complejidad a su perfil aromático. En contraste, en la vinificación, niveles elevados de estos compuestos son considerados un defecto que afecta negativamente a la calidad del vino.
Otro rasgo fenotípico de B. bruxellensis es la capacidad de formar biopelículas y de bioadhesión (adhesión a superficies). La capacidad de esta levadura para persistir en bodegas durante varios años, con contaminaciones recurrentes, sugiere que tiene propiedades específicas que le permiten sobrevivir en el entorno a través de fenómenos de bioadhesión. En un estudio realizado con más de 50 cepas representativas de los diferentes nichos de aislamiento de Brettanomyces, mostró que la mayoría de las cepas tenían una carga superficial negativa y eran hidrofílicas, mientras que un subgrupo de cepas de cerveza aisladas de vino exhibió un comportamiento hidrofóbico. Por otro lado, también se estudió el efecto de factores bióticos y abióticos sobre la bioadhesión de Brettanomyces y se observó que la concentración de etanol y el pH parecía no tener un efecto significativo en las propiedades superficiales de la levadura, la formación de pseudohifas o la bioadhesión, mientras que los factores relacionados con la cepa y el grupo genético influenciaban fuertemente dichas propiedades.
Resistencia al dióxido de azufre (SO₂)
La resistencia al SO₂, un conservante comúnmente utilizado en la elaboración de vino, es uno de los rasgos fenotípicos más estudiados en Brettanomyces (Figura 2). Se ha descrito que las cepas de Brettanomyces aisladas de entornos vinícolas tienen una mayor resistencia al dióxido de azufre (SO₂) que las cepas aisladas de cerveza o bioetanol, lo que demuestra cómo la plasticidad genética puede influir en la capacidad de adaptación a las condiciones productivas. Por ejemplo, cepas como L0308 y AWRI1499 han mostrado tener altos niveles de resistencia, lo que representa un desafío importante para la industria vinícola.

En otro estudio de Lleixà y otros, en 2021, 64 cepas de B. bruxellensis aisladas de vinos procedentes de barricas en Cataluña, España, se evaluaron genética y fisiológicamente, y se observó una alta diversidad interespecífica que se correspondía con una gran variabilidad en la resistencia al SO₂ y en la producción de fenoles volátiles entre las cepas. De hecho, el estudio de Bartel y otros (2021) demostró la capacidad de B. bruxellensis para evolucionar adaptativamente en respuesta a la exposición a sulfito, con el gen SSU1 como principal mecanismo de resistencia, el cuál aumentaría en número de copias según la exposición a este compuesto.
Estudios recientes han comenzado a desentrañar la base genética de estas diferencias fenotípicas, pero está claro que la diversidad genética de Brettanomyces juega un papel crucial en su impacto en los resultados de la fermentación.
Conclusión
La diversidad genética de Brettanomyces, especialmente B. bruxellensis, es un factor clave en su capacidad de adaptación y supervivencia en una amplia gama de entornos productivos. Esta diversidad, impulsada por la variación en la ploidía, la plasticidad genómica y la hibridación, permite a la levadura prosperar en condiciones desafiantes, como fermentaciones de cerveza con alto contenido de etanol o vinos tratados con SO₂. Comprender la diversidad genética y fenotípica de Brettanomyces es esencial para gestionar su papel en la fermentación industrial, ya sea como un organismo de deterioro o como una herramienta valiosa para obtener perfiles de fermentación únicos. A medida que los investigadores desentrañen los fundamentos genéticos de la diversidad de Brettanomyces, se estará en mejor disposición para desarrollar estrategias que permitan utilizar o mitigar sus efectos, dependiendo del contexto productivo en el que se encuentre. El avance en el conocimiento de la biología evolutiva de esta levadura mediante el desarrollo de herramientas genéticas más sofisticadas permitirá optimizar su uso en procesos de fermentación y mitigar sus posibles desventajas.
Fuente: ACE Enología – Autores: María C. Portillo, Gemma Beltrán y Maria-Jesús Torija de la Universitat Rovira i Virgili, Departament de Bioquímica i Biotecnologia, Facultat d’Enologia, Grup de Biotecnologia Enològica, Tarragona, España